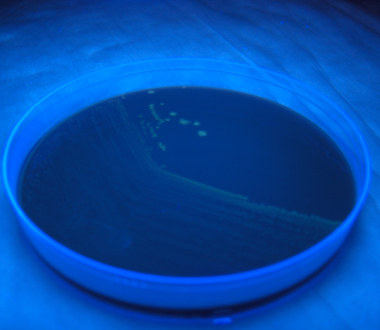

What can this tool do for me?
It can tell you which labs perform a certain test, the name of the labs and where they are located.
You can find tests performed within a given category for each approved lab and which sample type those tests can be performed on.